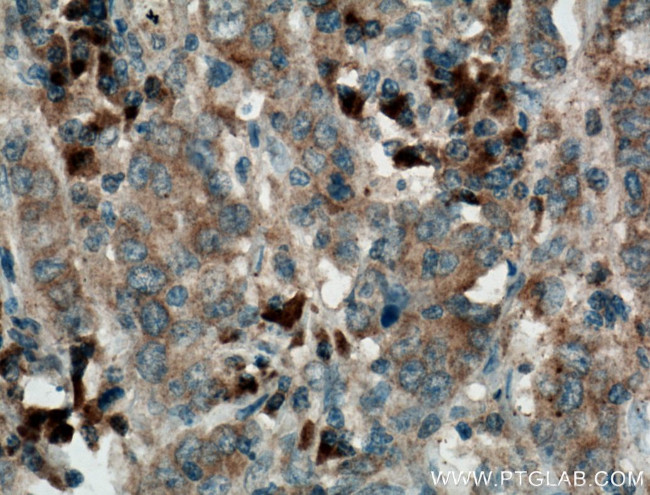
Pepsinogen II Antibody in Immunohistochemistry (Paraffin) (IHC (P))

Search
Proteintech
Pepsinogen II Polyclonal Antibody
{{$productOrderCtrl.translations['antibody.pdp.commerceCard.promotion.promotions']}}
{{$productOrderCtrl.translations['antibody.pdp.commerceCard.promotion.viewpromo']}}
{{$productOrderCtrl.translations['antibody.pdp.commerceCard.promotion.promocode']}}: {{promo.promoCode}} {{promo.promoTitle}} {{promo.promoDescription}}. {{$productOrderCtrl.translations['antibody.pdp.commerceCard.promotion.learnmore']}}
产品信息
16881-1-AP
种属反应
宿主/亚型
分类
类型
抗原
偶联物
形式
浓度
规格
纯化类型
保存液
内含物
保存条件
运输条件
产品详细信息
Immunogen sequence: MKWMVVVLV CLQLLEAAVV KVPLKKFKSI RETMKEKGLL GEFLRTHKYD PAWKYRFGDL SVTYEPMAYM DAAYFGEISI GTPPQNFLVL FDTGSSNLWV PSVYCQSQAC TSHSRFNPSE SSTYSTNGQT FSLQYGSGSL TGFFGYDTLT VQSIQVPNQE FGLSENEPGT NFVYAQFDGI MGLAYPALSV DEATTAMQGM VQEGALTSPV FSVYLSNQQG SSGGAVVFGG VDSSLYTGQI YWAPVTQELY WQIGIEEFLI GGQASGWCSE GCQAIVDTGT SLLTVPQQYM SALLQATGAQ EDEYGQFLVN CNSIQNLPSL TFIINGVEFP LPPSSYILSN NGYCTVGVEP TYLSSQNGQP LWILGDVFLR SYYSVYDLGN NRVGFATAA (1-388 aa encoded by BC073740 )
靶标信息
This gene encodes an aspartic proteinase that belongs to the peptidase family A1. The encoded protein is a digestive enzyme that is produced in the stomach and constitutes a major component of the gastric mucosa. This protein is also secreted into the serum. This protein is synthesized as an inactive zymogen that includes a highly basic prosegment. This enzyme is converted into its active mature form at low pH by sequential cleavage of the prosegment that is carried out by the enzyme itself. Polymorphisms in this gene are associated with susceptibility to gastric cancers. Serum levels of this enzyme are used as a biomarker for certain gastric diseases including Helicobacter pylori related gastritis. Alternate splicing results in multiple transcript variants. A pseudogene of this gene is found on chromosome 1.
仅用于科研。不用于诊断过程。未经明确授权不得转售。
篇参考文献 (0)
生物信息学
蛋白别名: Gastricsin; pepsin C; Pepsinogen C; pepsinogen group II; preprogastricsin; unnamed protein product; Urinary pepsinogen 1
基因别名: 2210410L06Rik; PEPC; Pg-1; PG1; PGC; PGII; Upg-1; Upg1
UniProt ID: (Human) P20142, (Mouse) Q9D7R7, (Rat) P04073
Entrez Gene ID: (Human) 5225, (Mouse) 109820, (Rat) 24864